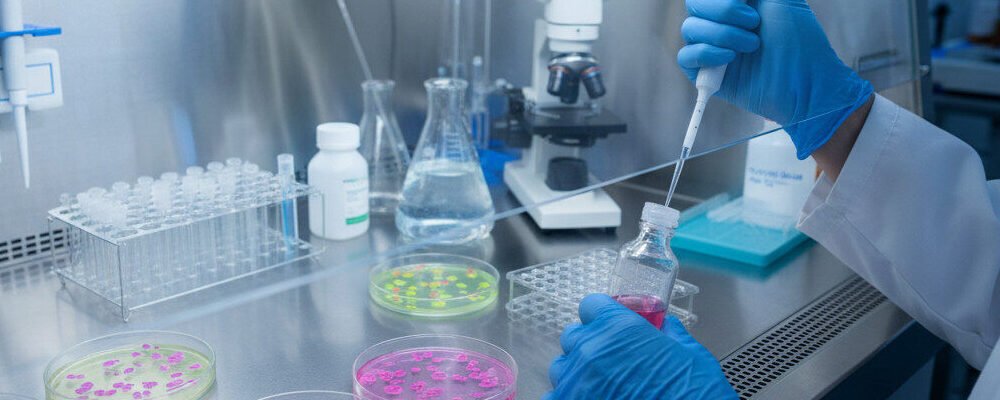
traducción de protocolos de cultivos celulares

📌 En pocas palabras
La traducción de protocolos de cultivos celulares exige precisión técnica y consistencia terminológica para evitar desviaciones en condiciones de cultivo, medios, reactivos y controles. Estos documentos son clave en I+D, biotecnología y entornos regulados, donde la reproducibilidad y la trazabilidad dependen de instrucciones claras.
En BeTranslated, traducimos protocolos celulares con enfoque científico, control de unidades y nomenclatura, y confidencialidad, para que puedan aplicarse con seguridad en laboratorios multicentro y proyectos internacionales.
Traducción de protocolos de cultivos celulares: sin margen para la desviación
En investigación con cultivos celulares, cada parámetro importa. Una instrucción mal traducida sobre concentración de reactivos, tiempo de incubación o condiciones de esterilidad puede invalidar un experimento completo, comprometer muestras valiosas o generar riesgos para el personal de laboratorio.
37 °C, 5 % CO₂, pH y osmolaridad: parámetros que no admiten ambigüedad
Los protocolos de cultivos celulares exigen precisión absoluta en temperatura, CO₂, pH y osmolaridad; cualquier desviación por error de traducción compromete la viabilidad celular y la reproducibilidad experimental.
Normas técnicas cultivos celulares BSL-2 – NTP 902, INSST
En BeTranslated trabajamos con SOPs, manuales de laboratorio, cuadernos electrónicos, flujogramas, Word, PDF e InDesign. Cubrimos las combinaciones lingüísticas más demandadas en ciencias de la vida: español, inglés, francés, alemán, italiano, portugués, neerlandés, árabe y chino.
Traducción científica especializada vs. traducción general
Una traducción científica no es cambiar palabras de un idioma a otro. Es un proceso técnico que requiere comprensión profunda del contexto, la terminología y los formatos propios de la biotecnología y la biología celular.
Cuándo es imprescindible
- Protocolos para estudios multicéntricos en UE o EE. UU.
- Documentación para EMA, FDA o AEMPS
- Transferencia de tecnología entre laboratorios internacionales
- Patentes en biotecnología o terapias celulares
- Publicación en revistas científicas de alto impacto
- Formación de personal en centros de investigación extranjeros

Riesgos concretos de una traducción imprecisa
En cultivos celulares primarios y líneas celulares, cada paso es crítico. Un error de traducción puede generar contaminación, resultados inconsistentes, pérdida de muestras o riesgos para el personal.
DMEM, RPMI1640, FBS: concentraciones que no admiten imprecisión
DMEM, RPMI1640, FBS 10 %, pen/strep 1 %, L-glutamina 2 mM requieren concentraciones exactas; una traducción imprecisa de composiciones de medios causa mortalidad celular masiva y fracaso experimental.
Procedimientos básicos de cultivo celular – Sigma-Aldrich
Nuestros traductores garantizan que la terminología científica y las instrucciones técnicas sean impecables, preservando la lógica científica y las implicaciones regulatorias de cada paso.
Reproducibilidad y trazabilidad: dos requisitos no negociables
Para que un descubrimiento sea validado globalmente, los experimentos deben poder replicarse en diferentes laboratorios. Los SOPs de cultivos celulares deben conservar secuencia temporal, condiciones ambientales y parámetros críticos para su validación internacional.
Trazabilidad GLP: número de pasaje, densidad, viabilidad y morfología
Número de pasaje, densidad de siembra, viabilidad post-tripsina, morfología observada y tiempo de duplicación deben registrarse con exactitud en todos los idiomas para auditorías GLP y transferencia de tecnología.
Normativa uso unidades celulares – BOE
Equipo especializado y proceso de calidad
Contamos con traductores biólogos, bioquímicos y expertos en biotecnología, hablantes nativos de la lengua meta, con conocimiento profundo de la terminología de cultivos celulares y las normativas del sector.
Terminología IUPAC/ISO: subcultivo, criopreservación, tripsinización, confluencia
Subcultivo/pasaje, criopreservación, tripsinización, confluencia y contaminación cruzada deben usar nomenclatura IUPAC/ISO validada; las ambigüedades terminológicas invalidan protocolos multicentro.
Estándares terminológicos de laboratorio celular – IUPAC
Nuestro proceso se alinea con los estándares de la norma ISO 17100: traducción por especialista, revisión por un segundo lingüista independiente y control de calidad final. Usamos herramientas CAT y memorias de traducción para garantizar coherencia en proyectos a largo plazo.
Gestión documental multiformato
Trabajamos con archivos InDesign con gráficos y diagramas, Word con tablas, PDF, flujogramas y cuadernos electrónicos. El documento traducido conserva estructura y presentación original, listo para su uso inmediato en el laboratorio.
Otros documentos científicos que traducimos
Además de los protocolos de cultivos celulares, cubrimos toda la documentación asociada al ciclo de investigación en ciencias de la vida:
| Tipo de documento | Área de aplicación |
|---|---|
| Informes de caracterización de proteínas | Desarrollo de fármacos y terapias moleculares |
| Secuencias genómicas y anotaciones | Investigación genética y medicina personalizada |
| SOPs y manuales de laboratorio | Estandarización de procedimientos experimentales |
| Protocolos de investigación | Ensayos clínicos y estudios multicéntricos |
| Informes de síntesis química | Industria química y desarrollo de APIs |
| Informes técnicos científicos | I+D y transferencia de tecnología |
| Revisiones sistemáticas y metaanálisis | Síntesis de evidencia científica |
| Tesis doctorales científicas | Universidades y centros de investigación |
| Informes de ensayos clínicos | CROs, laboratorios farmacéuticos, regulación |
| Monografías científicas | Publicaciones académicas y editoriales |
Si tu proyecto combina varios de estos documentos, podemos gestionarlos con un equipo coordinado y un glosario terminológico compartido, garantizando coherencia en todas las entregas.
Confidencialidad y protección de datos
Los protocolos de cultivos celulares contienen información propietaria sobre líneas celulares, composiciones de medios y procedimientos patentables. Todos nuestros traductores firman acuerdos de confidencialidad (NDA) antes de acceder a cualquier documento, y cumplimos con el Reglamento General de Protección de Datos (RGPD).
Autenticación STR e identidad de líneas celulares: la traducción errónea invalida datos
La autenticación STR, el micoplasma testing y la identidad de líneas celulares (HEK293, CHO, Jurkat) deben especificarse con exactitud; una traducción errónea causa uso incorrecto de líneas y datos inválidos.
Control de calidad de líneas celulares – ATCC
Nuestros protocolos de seguridad incluyen plataformas de gestión de proyectos cifradas, control de acceso restringido y copias de seguridad regulares.
🧫 ¿Necesitas traducir protocolos de cultivos celulares?
En BeTranslated, combinamos traducción científica y control terminológico para entregar protocolos claros, consistentes y listos para su uso en I+D, bioprocesos y laboratorios internacionales, con máxima confidencialidad.
Preguntas frecuentes
¿Por qué es importante una traducción especializada de protocolos de cultivos celulares?
Los protocolos de cultivos celulares contienen instrucciones técnicas detalladas. Una traducción especializada garantiza que cada parámetro experimental se exprese con precisión, evitando errores que puedan comprometer la validez de los resultados.
¿Qué formatos de archivo se aceptan?
Word, PDF, Excel, PowerPoint, InDesign, flujogramas y cuadernos electrónicos de laboratorio. También es posible traducir documentos escaneados, previa evaluación.
¿Cuánto tiempo tarda la traducción de un protocolo?
El plazo depende de la extensión, complejidad técnica, formato y combinación de idiomas. Tras revisar el documento, se facilita un plazo estimado. Existen opciones de entrega urgente cuando el proyecto lo requiere.
¿Cómo se garantiza la calidad técnica de la traducción?
Las traducciones se asignan a especialistas en ciencias de la vida, siguen procesos alineados con los estándares ISO 17100, incorporan revisión experta y control terminológico, y pasan un control final para asegurar precisión, coherencia y adecuación científica.
¿Traducís protocolos para terapias CAR-T o cultivos 3D?
Sí, contamos con traductores especializados en terapias avanzadas, cultivos 3D, organoides y modelos celulares complejos, con dominio de la terminología técnica y regulatoria.
¿Quién debe traducir protocolos de cultivos celulares?
Lingüistas especializados con formación en ciencias de la vida y conocimiento práctico de técnicas de laboratorio y terminología biomédica. En BeTranslated, todos nuestros traductores cumplen este perfil.